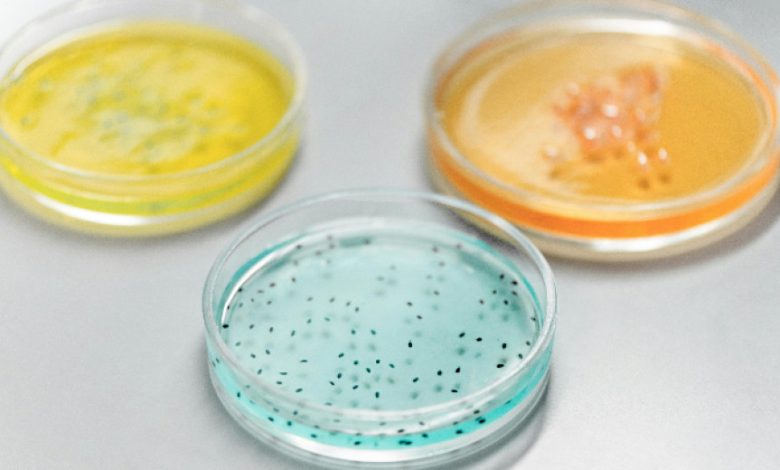

Бактериите бързо успяват да развият резистентност към нови антибиотици, сочи изследване по темата, цитирано от научното списание „Сайънс“.
Учените са изследвали как Стафилококус ауреус (Staphylococcus aureus) функционира спрямо антибиотични препарати, които все още не са пуснати на пазара. Бактерията причинява множество инфекции, които са устойчиви на антибиотици. Патогенът лесно развил резистентност към седем от осем лекарствени кандидати. Устойчивост се е появила включително към медикаменти, за които преди се е смятало, че са гарантирано ефективни.
Освен това патогенът не е имал нужда от нови мутации, за да стане резистентен, уточнява екипът от учени. Вместо това бактерията се е възползвала от генетични вариации, които вече са били налични в естествени бактериални популации. Като дори по-тревожен факт изданието „Сайънс“ откроява това, че някои вече одобрени антибиотици са помогнали на Стафилококус ауреус да развие устойчивост и към други лекарства, което е т.нар. кръстосана резистентност.
Не на последно място, в процеса на приспособяване патогенът не загубил по никакъв начин от силата на своята болестотворност и продължил да е все така опасен.
„От най-висока важност е да бъдат очаквани възможни пътища към резистентност, особено по време на ранните етапи на разработване на антибактериални лекарства“, препоръчват учените.
Според Световната здравна организация антимикробната резистентност е огромна заплаха за общественото здраве, а съгласно скорошен доклад около 40 милиона души годишно ще умират заради причинени от нея инфекции към 2050 година.
Източник: БНР





